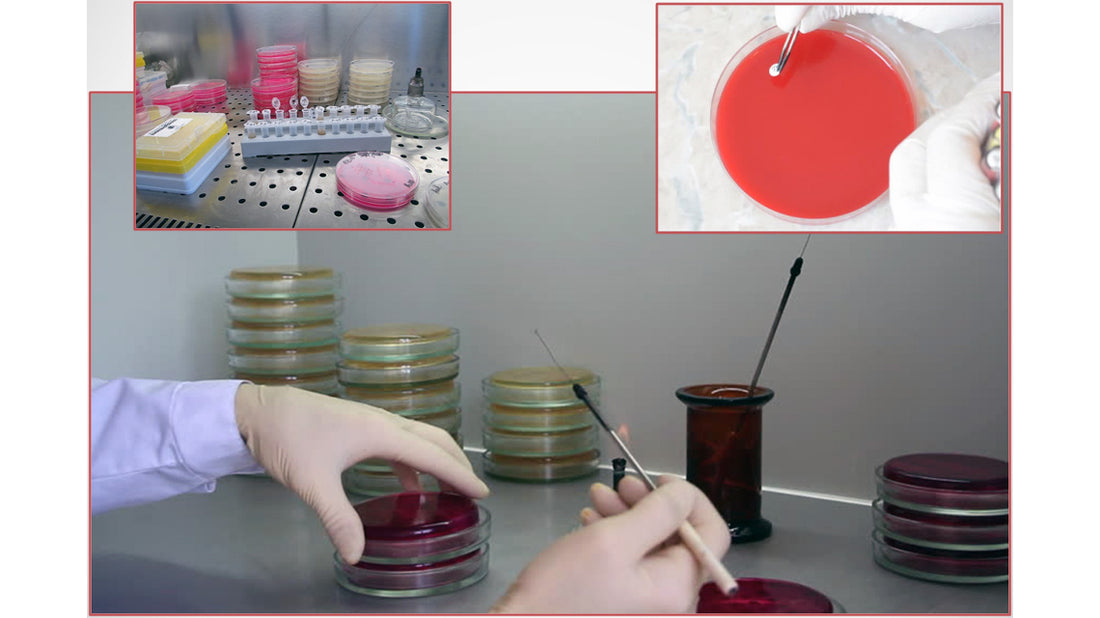

Πλήθος επιστημόνων στο 15ο Επιστημονικό Συνέδριο Ελληνικής Βοτανικής Εταιρείας
Share
Στο Συνεδριακό Κέντρο του Μεσογειακού Αγρονομικού Ινστιτούτου Χανίων, από 14 έως 17 Σεπτεμβρίου, έλαβε χώρα το 15ο Πανελλήνιο Επιστημονικό Συνέδριο της Ελληνικής Βοτανικής Εταιρείας, όπου παρουσιάστηκε το πρώτο κομμάτι της επιστημονικής έρευνας που διεξάγει η Mellifora σε συνεργασία με επιστημονικά ιδρύματα.
Το Συνέδριο συνδιοργάνωσε η Ελληνική Βοτανική Εταιρεία και το Μεσογειακό Αγρονομικό Ινστιτούτο Χανίων, με τη στήριξη της Περιφέρειας Κρήτης και του Δήμου Χανίων.

Η Δρ. Μαμούχα Σταυρούλα παρουσίασε μέρος των πειραματικών αποτελεσμάτων από την εργασία μας "Τα Ελληνικά Αρωματικά και Φαρμακευτικά Φυτά αποτελούν τη βάση για την δημιουργία φυσικών καλλυντικών προϊόντων". Η παρουσίαση πήγε πολύ καλά, οι παρευρισκόμενοι επιστήμονες παρακολούθησαν με πολύ ενδιαφέρον και υπέβαλαν ερωτήσεις καθώς και τα συγχαρητήριά τους.
Ολόκληρη την παρουσίαση της έρευνας όπως παρουσιάστηκε στο συνέδριο μπορείτε να τη βρείτε στο σύνδεσμο εδώ.
Eίμαστε ιδιαίτερα χαρούμενοι διότι τα πρώτα αποτελέσματα δείχνουν ότι πλήθος των φυσικών συστατικών που χρησιμοποιούμε κατά τη παρασκευή των καλλυντικών μας έχουν ισχυρή βιολογική δράση.
Η έρευνα συνεχίζεται και θα τα αποτελέσματα του 2ου κύκλου των πειραμάτων θα ανακοινωθούν στο 7ο Πανελλήνιο Συνέδριο Ελληνικής Εταιρείας Ιατρικής Μυκητολογίας.